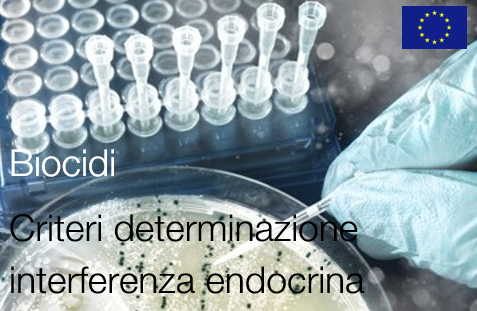
Regolamento 2017 2100

Regolamento delegato (UE) 2017/2100
| ID 4994 | | Visite: 4479 | Regolamento BPR | Permalink: https://www.certifico.com/id/4994 |
Biocidi: Criteri scientifici determinazione interferenza con il sistema endocrino
Regolamento delegato (UE) 2017/2100 della Commissione del 4 settembre 2017 che stabilisce criteri scientifici per la determinazione delle proprietà di interferenza con il sistema endocrino in applicazione del regolamento (UE) n. 528/2012 del Parlamento europeo e del Consiglio
Articolo 1
I criteri scientifici per la determinazione delle proprietà di interferenza con il sistema endocrino in applicazione del regolamento (UE) n. 528/2012 sono stabiliti nell'allegato del presente regolamento.
Articolo 2
I criteri di cui all'allegato del presente regolamento si applicano a decorrere dal 7 giugno 2018, salvo nel caso delle procedure per le quali il comitato di cui all'articolo 82 del regolamento (UE) n. 528/2012 abbia espresso un voto su un progetto di regolamento entro il 7 giugno 2018.
Articolo 3
Entro il 7 giugno 2025 la Commissione presenta al gruppo di esperti (la «riunione delle autorità competenti per i biocidi»), composto da rappresentanti delle autorità competenti degli Stati membri per i biocidi, una valutazione dell'esperienza acquisita nell'applicazione dei criteri scientifici per la determinazione delle proprietà di interferenza con il sistema endocrino introdotti dal presente regolamento.
__________
ALLEGATO
Si considera sostanza avente proprietà di interferenza con il sistema endocrino degli esseri umani o di organismi non bersaglio una sostanza che soddisfa i criteri di cui alla sezione A o alla sezione B.
Sezione A - Proprietà di interferenza con il sistema endocrino degli esseri umani
(1) Si considera sostanza avente proprietà di interferenza con il sistema endocrino che possono avere effetti nocivi negli esseri umani una sostanza che, sulla base del punto 2, lettere da a) a d), soddisfa tutti i seguenti criteri, salvo in presenza di dati che dimostrino che gli effetti nocivi identificati non sono pertinenti per gli esseri umani:
a) produce un effetto nocivo su un organismo integro o sulla sua progenie, ossia provoca un cambiamento — a livello di morfologia, fisiologia, crescita, sviluppo, riproduzione o ciclo vitale di un organismo, un sistema o una (sotto)popolazione — che causa una riduzione della capacità funzionale, della capacità di compensare ulteriori stress o un aumento della suscettibilità ad altri fattori;
b) presenta un meccanismo d'azione endocrino, ossia altera la funzione o le funzioni del sistema endocrino;
c) l'effetto nocivo è una conseguenza del meccanismo d'azione endocrino.
(2) L'identificazione di una sostanza come avente proprietà di interferenza con il sistema endocrino che possono avere effetti nocivi negli esseri umani conformemente al punto 1 si basa su tutti i punti seguenti:
a) tutti i pertinenti dati scientifici disponibili (studi in vivo o sistemi di prova alternativi adeguatamente convalidati predittivi degli effetti nocivi negli esseri umani o negli animali, e studi in vivo, in vitro o, se pertinente, in silico, che forniscano informazioni sui meccanismi d'azione endocrini):
i) dati scientifici prodotti conformemente a protocolli di studio concordati a livello internazionale, in particolare quelli di cui agli allegati II e III del regolamento (UE) n. 528/2012;
ii) altri dati scientifici selezionati mediante l'applicazione di una metodologia di riesame sistematico;
b) una valutazione di tutti i pertinenti dati scientifici disponibili utilizzando un approccio basato sulla forza probante dei dati al fine di stabilire se i criteri di cui al punto 1 sono soddisfatti; nel determinare la forza probante dei dati, la valutazione dei dati scientifici presta particolare attenzione a tutti i seguenti fattori:
i) i risultati negativi e positivi;
ii) la pertinenza dei disegni di studio per la valutazione degli effetti nocivi e del meccanismo d'azione endocrino;
iii) la qualità e la coerenza dei dati, considerate la configurazione e la coerenza dei risultati in studi di disegno analogo, tra studi di disegno analogo e tra diverse specie;
iv) studi riguardanti la via di esposizione, la tossicocinetica e il metabolismo;
v) il concetto di dose limite e le linee guida internazionali sulle dosi massime raccomandate e sulla valutazione degli effetti di confondimento dell'eccessiva tossicità;
c) utilizzando un approccio basato sulla forza probante dei dati, il nesso tra gli effetti nocivi e il meccanismo d'azione endocrino è stabilito sulla base della plausibilità biologica, che viene determinata alla luce delle attuali conoscenze scientifiche e in considerazione di orientamenti concordati a livello internazionale;
d) gli effetti nocivi che sono conseguenze secondarie non specifiche di altri effetti tossici non sono presi in considerazione per l'identificazione della sostanza come interferente endocrino.
Sezione B - Proprietà di interferenza con il sistema endocrino di organismi non bersaglio
(1) Si considera sostanza avente proprietà di interferenza con il sistema endocrino che possono avere effetti nocivi negli organismi non bersaglio una sostanza che, sulla base del punto 2, lettere da a) a d), soddisfa tutti i seguenti criteri, salvo in presenza di dati che dimostrino che gli effetti nocivi identificati non sono pertinenti a livello di (sotto) popolazione per gli organismi non bersaglio:
a) produce un effetto nocivo in organismi non bersaglio, ossia provoca un cambiamento — a livello di morfologia, fisiologia, crescita, sviluppo, riproduzione o ciclo vitale di un organismo, un sistema o una (sotto)popolazione — che causa una riduzione della capacità funzionale, della capacità di compensare ulteriori stress o un aumento della suscettibilità ad altri fattori;
b) presenta un meccanismo d'azione endocrino, ossia altera la funzione o le funzioni del sistema endocrino;
c) l'effetto nocivo è una conseguenza del meccanismo d'azione endocrino.
(2) L'identificazione di una sostanza come avente proprietà di interferenza con il sistema endocrino che possono avere effetti nocivi negli organismi non bersaglio conformemente al punto 1 si basa su tutti i punti seguenti:
a) tutti i pertinenti dati scientifici disponibili (studi in vivo o sistemi di prova alternativi adeguatamente convalidati predittivi degli effetti nocivi negli esseri umani o negli animali, e studi in vivo, in vitro o, se pertinente, in silico, che forniscano informazioni sui meccanismi d'azione endocrini):
i) dati scientifici prodotti conformemente a protocolli di studio concordati a livello internazionale, in particolare quelli di cui agli allegati II e III del regolamento (UE) n. 528/2012;
ii) altri dati scientifici selezionati mediante l'applicazione di una metodologia di riesame sistematico;
b) una valutazione di tutti i pertinenti dati scientifici disponibili utilizzando un approccio basato sulla forza probante dei dati al fine di stabilire se i criteri di cui al punto 1 sono soddisfatti; nel determinare la forza probante dei dati, la valutazione dei dati scientifici presta attenzione a tutti i seguenti fattori:
i) i risultati positivi e negativi, se del caso distinguendo tra gruppi tassonomici diversi (ad esempio mammiferi, uccelli, pesci e anfibi);
ii) la pertinenza del disegno di studio per la valutazione degli effetti nocivi, la sua pertinenza a livello di (sotto) popolazione e per la valutazione del meccanismo d'azione endocrino;
iii) gli effetti nocivi sulla riproduzione, sulla crescita/sullo sviluppo e altri effetti nocivi pertinenti che probabilmente avranno un impatto sulle (sotto)popolazioni. Sono altresì considerati, se disponibili, i dati raccolti sul campo o di monitoraggio e/o i risultati ottenuti da modelli di popolazioni appropriati, attendibili e rappresentativi;
iv) la qualità e la coerenza dei dati, considerate la configurazione e la coerenza dei risultati in studi di disegno analogo, tra studi di disegno analogo e tra diversi gruppi tassonomici;
v) il concetto di dose limite e le linee guida internazionali sulle dosi massime raccomandate e sulla valutazione degli effetti di confondimento dell'eccessiva tossicità;
c) utilizzando un approccio basato sulla forza probante dei dati, il nesso tra gli effetti nocivi e il meccanismo d'azione endocrino è stabilito sulla base della plausibilità biologica, che viene determinata alla luce delle attuali conoscenze scientifiche e in considerazione di orientamenti concordati a livello internazionale;
d) gli effetti nocivi che sono conseguenze secondarie non specifiche di altri effetti tossici non sono presi in considerazione per l'identificazione della sostanza come interferente endocrino per organismi non bersaglio.
(3) Se il meccanismo d'azione biocida previsto della sostanza attiva oggetto di valutazione consiste nel controllo di organismi bersaglio diversi dai vertebrati attraverso i loro sistemi endocrini, gli effetti sugli organismi appartenenti allo stesso phylum tassonomico dell'organismo bersaglio non vengono considerati per l'identificazione della sostanza come avente proprietà di interferente endocrino per gli organismi non bersaglio.
GUUE L 301/1 del 17.11.2017
Entrata in vigore: 07.12.2017
Applicazione: 07.06.2018
Correlati:
Tags: Chemicals Regolamento BPR